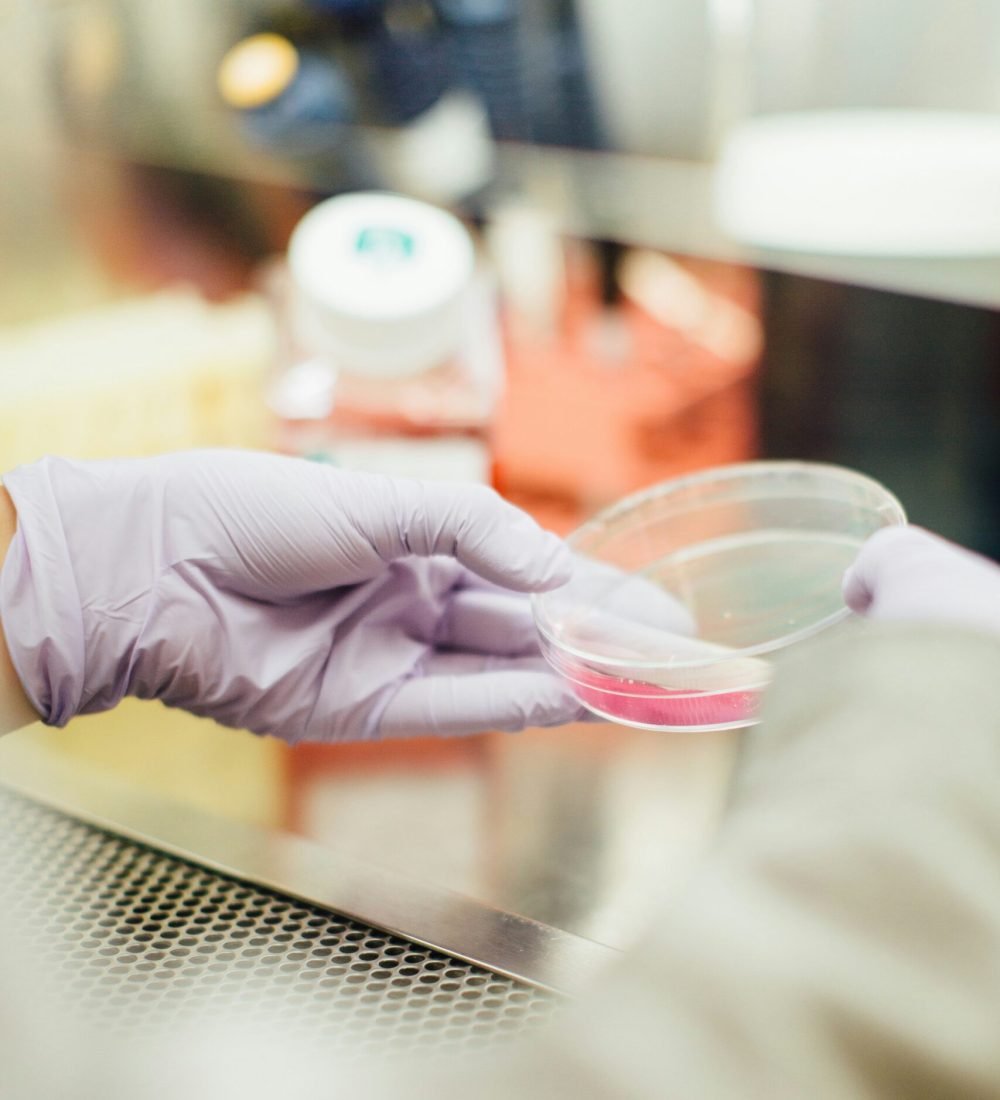
drew-tGYrlchfObE-unsplash

Flexible Business Development & Corporate Finance Support in Life Sciences
Get matched with a Tier-1 Independent Operator in less than 72 hours
Our expertise
We support Life Sciences companies across the entire lifecycle, from early spin-off formation and seed fundraising, through clinical development strategy, to commercialization and exit preparation.
Wherever you are on your growth journey, our consultants bring the expertise to accelerate execution.
Business Development
- R&D-based Partnerships
- Licensing Preparations
- Clinical Roadmap
- Indication Prioritisation
Corporate Finance
- (Pre-)seed Fundraising
- Spin-off Formation
- Pitch & Equity Story Development
- Non-Dilutive Funding
Business Development
- Indication Prioritisation
- Strategic Partnerships
- Go-to-Market Strategy
- Pipeline Evaluation
- Commercial Due Diligence
Corporate Finance
- Series A+ Fundraising
- Valuation & Financial Modelling
- M&A / exit support
- Board Materials
- Clinical Financial Planning
Business Development
- Search & Evaluation
- Go-to-Market Execution
- Acquisition Due Diligence
- Portfolio Expansion & Optimisation
- Market Access & Pricing Strategy
Corporate Finance
- M&A / Exit
- IPO Preparation
- Investor Relations
- Strategic Divestments
- Valuation & Financial Modelling
You are in good company
Our consultants have prior experience at Tier-1 Venture Capital Funds, Investment Banks, Consultancies and Life Science companies.











Our values
We are a community of ambitious hands-on operators with a deep sense of ownership and relentless pursuit of making an impact.
Passion for Life Science Innovation
Committed to high quality standards
Deep expertise
(>5 years in LS)
Clear direction and momentum
Acting fast on opportunities
Ambitions for global impact
A better consulting model in Life Sciences
LS-Match offers companies direct access to carefully selected, hands-on independent consultants at fair, transparent rates, without the overhead and rigidity of traditional firms.
You stay in control of who executes your project, with the option to hire top talent permanently if there’s a great fit.
LS-Match
- You hand-pick each consultant
- Hands-on operators
- Flexible project scope
- Fairly & flexibly priced
- Ability to convert to employee
Traditional Consulting
- You don’t control who executes
- Significant overhead
- Fixed project scope
- Expensive, often with retainers
- Non-poaching clause
Case Studies
How we deliver targeted, hands-on support at critical inflection points, helping life sciences teams move faster, make better decisions, and execute high-stakes projects with confidence.

LS-Match supported a US-based Phase 2 oncology biotech in preparing for a Series B to fund pipeline expansion.
We provided hands-on C-suite level fundraising support, including refining the equity story, investor materials, and strategic outreach planning for key conferences and partners.
The company was matched with a Tier-1 investment banking alum with deep life sciences fundraising and corporate finance expertise, enabling focused and execution-driven support alongside a lean internal team.
LS-Match supported a Dutch hospital-based R&D team developing a novel CNS application in preparing an early-stage discovery grant application within a biotech program.
We matched them with a former VC investor who led the process and provided hands-on support across market opportunity assessment, budget conceptualisation, and grant writing.
This allowed the team to submit a more structured and competitive application while staying focused on their scientific and clinical work.
How does it work?
From first contact to starting execution, we match you with the ideal operator for your business and situation
- Project Scoping: We discuss your project needs and prepare a project description
- Candidate Pool: Project description is shared with the full pool of candidates
- Expression of Interest: Candidates can indicate their interest in your project
- Profile Sharing: We provide you with candidate profiles, and you decide whom you’d like to meet
- Final Agreement: Hourly fees and the consultancy contract are determined
Lets get your strategic project underway
Want to explore a project together? Get in touch with us today.

Kim Bruin
Co-founder LS-Match
kim@ls-match.com
+31-621-161-806

Mihail Cecan
Co-founder LS-Match
mihail@ls-match.com
+31-615-186-562
All Rights Reserved | LS-Match B.V.